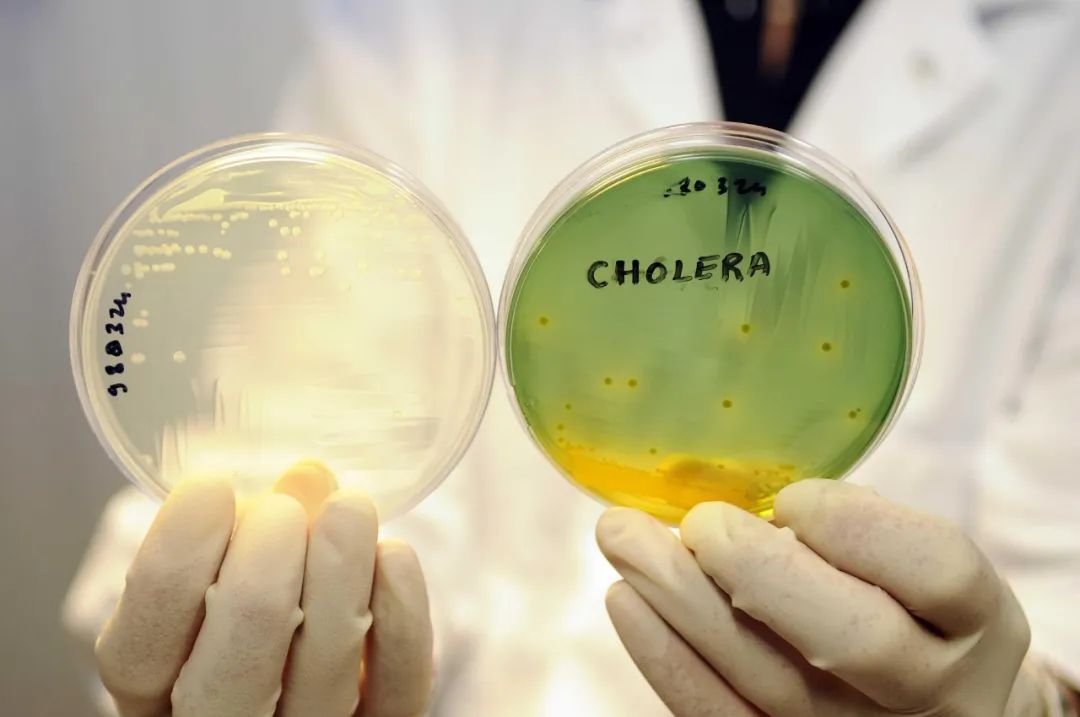

本文转自:上海新闻广播
微信号:shnews990
7月11日,武汉市武昌区卫生健康局就武汉大学一例霍乱病例处置情况进行通报。
为回应社会关切,武汉大学通过官方公众号,就该病例的相关情况进行答记者问。

据武汉大学介绍,该病例为武汉大学研究生,住工学部八舍,有胃肠炎既往病史。7月8日5时左右出现发热、呕吐、腹泻,7月8日10时前往武汉大学医院就诊,因其腹泻3次以上转诊至武汉大学中南医院。目前该生已按相关要求转诊至武汉大学人民医院隔离治疗。
据疾控部门反馈,该生新冠病毒核酸检测阴性,湖北省疾控中心和武汉市疾控中心对原样开展复核,血清学凝集试验均为O139阳性,诊断为霍乱,毒力基因阴性(霍乱弧菌致病力较弱),目前经有效诊治,该生情况稳定,症状已消失。
该生密接3人(同住室友2人、同餐人员1人),已转至学校隔离点集中隔离。截至7月10日19:36,通过对264名重点人群、259个点位进行快检,未检出O1、O139群霍乱弧菌,未发现新增病例。
对工学部八舍公共区域、宿舍、卫生间、排污管道,该生所在的实验室楼栋等封控后已开展环境采样和终末消毒。
目前,武汉大学各方面秩序良好,工作正常开展。感谢社会公众、广大校友对武汉大学的关心,也请广大师生不要恐慌,注意个人卫生,并做好自我健康监测。

消息一经确认
多条相关话题冲上热搜
除了病例的情况
网友们还关心
霍乱到底是什么病?
为何会被列为甲类传染病?
它是怎么传播的?
我们需要担心吗?
……



什么是霍乱?
为何会被列为甲类传染病?
霍乱(Cholera)是由O1群或O139群霍乱弧菌引起的急性肠道传染病,表现症状主要以腹泻为主,甚至肚子不疼就开始腹泻,也会伴有呕吐症状出现。被污染的水源及海产品都可以作为传播途径。剧烈腹泻往往对人体造成较大危害,会出现脱水等症状,迅速导致生命危险。
根据菌体(O)抗原的不同,霍乱弧菌可分出200个以上的O血清群,但仅发现O1和O139群霍乱弧菌能引发霍乱。
O1群霍乱弧菌包括两个生物型:古典生物型和埃尔托生物型,两个生物型又都分为稻叶、小川和彦岛(少见)三种血清型。O1和O139群霍乱弧菌可分为产毒株和非产毒株。

霍乱弧菌示意图
霍乱弧菌被人吃进肚子里,如果有少数可以活过胃酸这一关安稳到达肠道,就会在肠道里生存下来慢慢繁衍并且分泌霍乱毒素。霍乱毒素推动细胞内钠离子进入肠腔,使肠腔保持高渗透压状态,结果就导致身体的水分因为渗透压被大量吸入进肠道,肠道里储存大量水分,腹泻也就一发不可收拾。
这种严重的腹泻早期可能还有一点点粪便的黄色,后面就全是类似于淘米水一样的大便,最多时可以每小时 1 公斤以上的水分被疯狂排出。如果此时不给予及时的水分补充,人很快就会面临脱水接近死亡。

大流行期间,画家记录下的一名因霍乱而死的 23 岁女性。可以看到霍乱给死者留下了明显的脱水印迹。眼睛凹陷、皮肤起皱呈现蓝灰色。因此霍乱在那个年代也被称之为“蓝色死亡”。
由于具有发病急、传播快、波及面广等特点,所以被列为我国《传染病防治法》规定的两种甲类传染病之一(还有一种是鼠疫),也是《国际卫生检疫条例》规定国际检疫的三种传染病之一。
霍乱的七次大流行
自1817年以来,曾经发生过七次世界性霍乱大流行,先后导致数千万人死亡,对部分染疫地区的民众生命健康、经济发展、社会稳定等方面造成了毁灭性打击。
1817年至1923年的百余年间,在亚、非、欧、美、澳等发生的六次世界性霍乱大流行是由古典生物型引起的,给人类带来巨大的灾难。

德国汉堡市管理部门在霍乱大流行中分发开水
1961年开始的第七次世界性霍乱大流行,是由埃尔托生物型霍乱弧菌引起的,至今已波及五大洲140个以上的国家和地区,报告病例数在400万以上。
2010年11月16日,巴黎,法国国家霍乱病研究中心的工作人员正在分析霍乱病菌。研究中心需要对法国本土和国外不同菌株的霍乱病菌进行确认研究。
1992年10月印度和孟加拉相继发生一种由O139群霍乱弧菌引起的新型霍乱暴发和较大流行,这型霍乱随后在亚洲传播,至今已有印度、孟加拉、中国、巴基斯坦、泰国、马来西亚、缅甸、尼泊尔、新加坡、斯里兰卡、中国香港等国家和地区报告发生O139霍乱病例。
目前全球每年大约有300万~500万人感染霍乱,死亡人数达10~12万。

当地时间2014年5月14日,菲律宾棉兰老岛,患者在医院接受治疗。当地偏远村庄遭受霍乱威胁,至少9人死亡,超过600人住院。
历史上的几次霍乱大流行都曾波及到中国,其中尤以第六次大流行的影响严重。当时中国是清末民初年间,多地先后爆发疫情,以至于民间习惯用英语 Cholera 音译来的名字“虎烈拉”来称呼霍乱。虎烈拉三个字很直观地体现出了霍乱致命、发病迅疾、严重腹泻的特点。
当时的河南地区,虎烈拉大流行传播四十七县,患病达185251人,死亡46947人,病死率高达25%。
霍乱的传播途径是什么?
霍乱不会通过空气进行传播,也不能通过皮肤直接传播,主要通过粪口途径传播,简单来说,就是病从口入。但是如果皮肤沾染到霍乱弧菌,不注意卫生,不注意洗手,也有可能导致传染。
什么人容易感染霍乱?
不分种族、性别和年龄,人们对霍乱普遍易感,胃酸缺乏者尤其易感。病后可获得一定免疫力,但再感染的可能性依然存在。尤其是生活在卫生条件和医疗条件较差地区的人群,更是霍乱疾病的高发人群。

干净的淡水意味着非洲黑人儿童的生命
什么时候容易得霍乱?
霍乱在我国的流行时间为3至11月份,6至9月份是流行高峰。
霍乱的潜伏期和传染期多少?
潜伏期数小时至5天,通常2至3天。粪便阳性期间有传染性,通常至恢复后几天。偶有携带者传染期持续数月。对霍乱弧菌有效的抗菌药物可缩短传染期。
如何发现自己感染霍乱?
有腹泻症状,尤其是剧烈的无痛性水样腹泻,应马上到医院就诊,并做霍乱弧菌的培养检查。与霍乱感染者一起就餐或密切接触的人也应采集粪便或肛拭检查,以确定是否感染。在霍乱疫区内或近日去过霍乱疫区,出现腹泻,应及时到医院就诊并留粪便作霍乱细菌学检查。
感染霍乱后应如何做?
霍乱传染性很强,一旦发现感染霍乱,无论是轻型还是带菌者,均应隔离治疗。霍乱症状消失,停服抗菌药物后,连续二天粪便培养未检出霍乱弧菌者才可解除隔离。感染霍乱后,不接受隔离治疗,属于违反《中华人民共和国传染病防治法》的行为,另外病人和带菌者要配合疾病预防控制中心工作人员做好流行病学调查、密切接触者的采样、家里疫点的消毒等工作。
霍乱的治疗措施
该病的处理原则是严格隔离,暂且尚无特效药物,只能进行对症处理,及时补充水及电解质,辅以抗菌治疗。剧烈呕吐者暂停进食,待呕吐、腹泻缓解后可给予流质饮食,同时应注意并发症的发生。
涉疫学生都完成了肛拭子检查
检查霍乱需要这么羞耻吗?
昨晚“武大出现霍乱”的消息传出,网友们纷纷关注到,“全栋学生都进行了统一肛拭子检测”。两个话题分列热搜第一和第二。

鼻咽拭子已经较为常见了,那么什么是肛拭子?为什么要做肛拭子呢?
肛拭子是在直肠采样进行检查的采样拭子,主要针对肠道内寄生虫或者细菌、病毒的检测,可用于诊断胃肠道传染病如细菌性痢疾,以及肛周疣、直肠淋病和HPV 感染等等。
按照我国霍乱诊断标准要求,对疑似患者需要进行粪便霍乱弧菌培养检查,培养出霍乱弧菌,然后血清分型分辨是 O1 还是 O139 群之后就能确诊,时间大概需要 48 小时。
粪便培养一般是直接粪便取样检查,但有时不方便马上排便,肛拭子插入肛门贴壁旋转也能取出少许粪便样本做检查。另外,借助于肛拭子取样,也有一些更快速的检测(RDT)能用来辅助诊断霍乱。
如何预防霍乱?
预防霍乱的方法比较简单。主要是“把好一张口”,注意饮食安全,预防病从口入。做到“五要五不要”——
五要:饭前便后要洗手,买回海产要煮熟,隔餐食物要热透,生熟食品要分开,出现症状要就诊。
五不要:生水未煮不要喝,无牌餐饮不光顾,腐烂食品不要吃,暴饮暴食不可取,未消毒(霍乱污染)物品不要碰。

此外也要加强个人防护,公民若前往霍乱疫情发生国家或地区,请尽量避免与霍乱确诊病例或疑似有霍乱症状者直接接触,如有不适,请主动申报以便及时医治。
可防可治,无需惊慌
新中国成立以来,随着爱国卫生运动的开展和医学水平的进步,霍乱在中国掀起的风浪也越来越小。
霍乱这种疾病在 1989 年被纳入法定报告传染病时发病数是数以千计,1994 年达到发病高峰,报告发病数 34027人,死亡 287 人,而后在 1998 年再次出现发病破万,而后整体呈下降趋势,甚至多年没有新发病例报告。2018~2021 年均有散在新发病例,但无人因此死亡。丁香医生公众号称:“有时候都觉得,霍乱的‘甲类传染病’头衔都有些名存实亡了。 ”

知名健康博主@普外科曾医生 也表示,“毒力基因阴性,说明不能产霍乱肠毒素,也就是非产毒株,致病能力弱,引起的症状轻,大家不用担心。霍乱可防可治,对卫生经济条件较好的国家来说,霍乱真的不可怕,大家勤洗手,不吃生食,搞好个人卫生即可。”
整体来说,霍乱是典型的“病从口入”传染病,预防的有效方法主要是培养良好卫生习惯。只要做到早发现、早报告、早诊断、早治疗,霍乱是不难治愈的。
上海新闻广播综合自武汉大学、都市快报、北京日报、丁香医生等